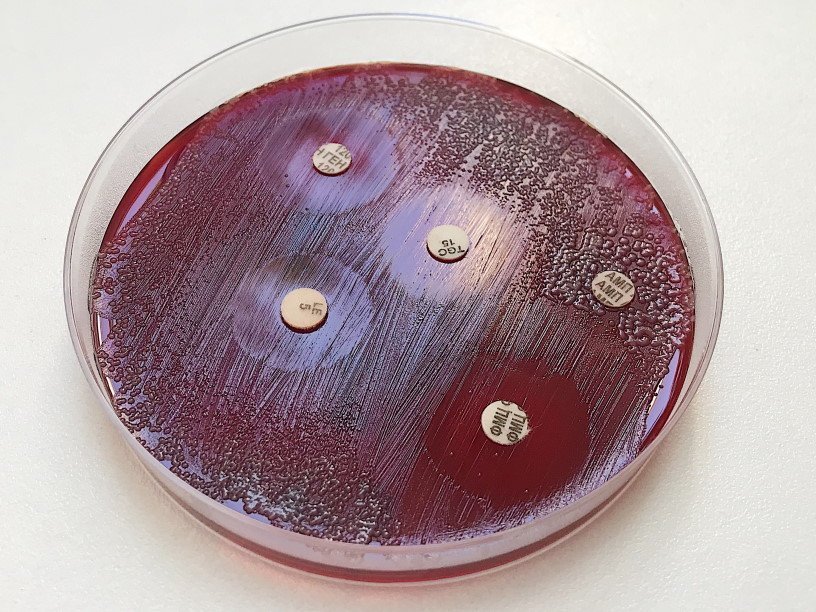

Екатерина Беленко: Промикробы: Красная и синяя таблетки
Диски, пропитанные антибиотиками, в чашке Петри с кровяным агаром Фото: Екатерина Беленко Антибиотики — это вещества, подавляющие рост живых клеток, чаще всего прокариотических, то есть бактерий. Антибиотики природного происхождения чаще всего продуцируются актиномицетами, реже — бактериями. Да-да, вы все правильно поняли — вещества против бактерий, но могут продуцироваться бактериями. Этот парадокс легко объяснить, если взглянуть на ситуацию не с высоты хомосапиенсовского эгоизма. Антибиотики не были чудесным образом придуманы для нас с вами. Антибиотики для микробов — это способ общения друг с другом, попытка сказать с помощью химических сигналов, что территория занята, тут тесно, и мало пищи. А мы лишь нагло пользуемся этим средством связи.
Некоторые антибиотики используются в качестве противоопухолевых препаратов при лечении онкологических заболеваний. Кроме того, антибиотики обычно не воздействуют на вирусы и поэтому бесполезны при лечении вызываемых вирусами заболеваний (например, гриппа, гепатита, ветряной оспы, герпеса, краснухи, кори). Так что давайте лечиться грамотно.
Как определить, каким антибиотиком лечить? Итак, если посев дал положительный результат, мы не останавливаемся на том, что определили возбудителя. Далее следует выяснить, к каким антибиотикам он чувствителен, а какие ему вообще пофиг. Чтобы это сделать, нужно выделенную культуру посеять сплошным газоном (да, это совершенно серьезное название техники микробиологического посева) на среду Мюллера-Хинтона. На фото не она, а кровяной агар, так иногда тоже делают. Затем по чашке раскладываем диски, пропитанные антибиотиками, — и в термостат. На следующий день смотрим на чашку и видим — вокруг одних антибиотиков наблюдаются зоны без роста, а вокруг других растет как ни в чем не бывало. Получается, если антибиотик работает против нашего микробика, то будет зона без роста, а если не работает, то микроб как Чак Норрис — растет где хочет. Далее зоны измеряются, и мы получаем результат, в котором:
S — значит чувствительно, то есть этим антибиотиком можно эффективно лечиться;
I — промежуточный результат;
R — устойчивый, то есть к этому антибиотику есть механизмы резистентности, лечиться им не надо.
Но результат бактериологического исследования — это не путевка в ближайшую аптеку. На основе нашего результата нужна консультация врача, ведь бесконтрольный прием антимикробных препаратов ведет к антибиотикорезистентности среди микроорганизмов, а это большущая проблема. Устойчивость к антибиотикам может быть как природной (вследствие отсутствия мишеней для антибиотика или невозможности ее достижения в микробной клетке), так и приобретенной. С природной устойчивостью поделать ничего нельзя, но она и не прогрессирует.
Приобретенная устойчивость возникает вследствие мутаций и под воздействием антибиотика закрепляется в популяции. Возникновению и поддержанию приобретенной устойчивости к антимикробным препаратам способствует неграмотное и бесконтрольное их использование, в частности, применение без назначения врача.
Микробики очень давно живут на нашей планете и очень давно используют антибиотики, но сейчас все изменилось. Человек вмешался и сместил равновесие. Гены устойчивости к антибиотикам распространились, а на самом деле оказались отобранными людьми и теперь обнаруживаются с высокой частотой у большинства патогенных бактерий. Это создает огромные трудности при лечении вызванных ими инфекций.
Смотрите также: Екатерина Беленко Промикробы: Волшебная палочка Екатерина Беленко Промикробы: Скрытые фигуры Екатерина Беленко Промикробы: Плесень и липовый мёд Екатерина Беленко Промикробы: Ода кишечной микрофлоре